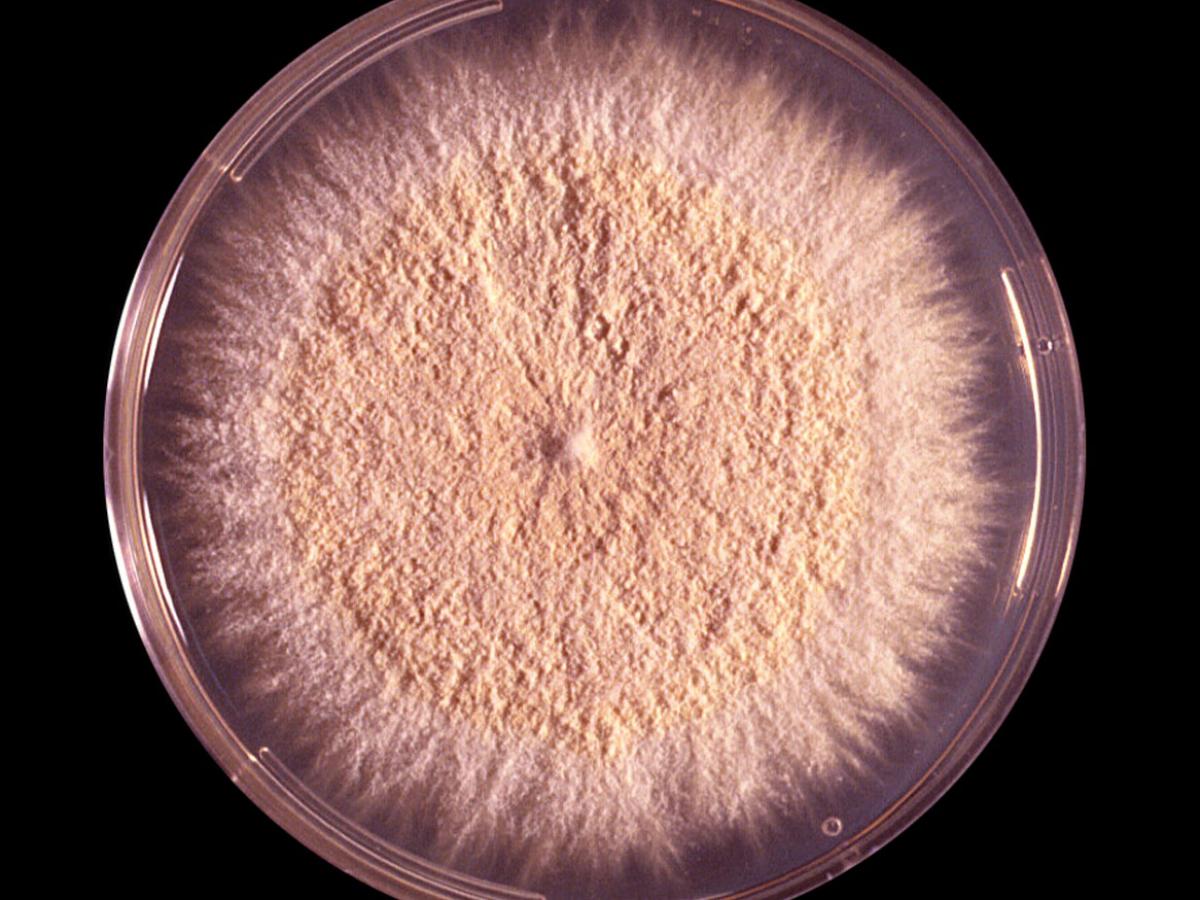
Culture

Status message
Correct! Excellent, you have really done well. Please find additional information below.
Unknown 21 = Nannizzia gypsea (formerly Microsporum gypseum)
Clinical presentation: A large, circular, erythematous pustular lesion on the wrist caused by N. gypsea.

Direct microscopy: KOH mount of infected hairs showing a large spored ectothrix invasion typically caused by N. gypsea.

Culture: On Sabouraud's dextrose agar, colonies are usually flat, spreading, suede-like to granular, with a deep cream to tawny-buff to pale cinnamon coloured red surface. Many cultures develop a central white downy umbo (dome) or a fluffy white tuft of mycelium and some also have a narrow white peripheral boarder. A yellow-brown pigment, often with a central darker brown spot, is usually produced on the reverse, however a reddish-brown reverse pigment may be present in some strains.
Microscopy: Cultures produce abundant, symmetrical, ellipsoidal, thin-walled, verrucose, 4-6 celled macroconidia. The terminal or distal ends of most macroconidia are slightly rounded, while the proximal ends (point of attachment to hyphae) are truncate. Numerous clavate shaped microconidia are also present, but these are not diagnostic.

Comment: Nannizzia gypsea is a geophilic fungus with a world-wide distribution which may cause infections in animals and humans, particularly children and rural workers during warm humid weather. Usually produces a single inflammatory skin or scalp lesion. Invaded hairs show an ectothrix infection but do not fluoresce under Wood's ultra-violet light.
About Nannizzia Back to virtual assessment